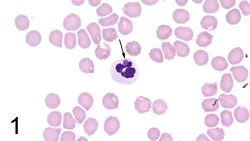
Featured Image

A six-year-old, intact male German shepherd was presented to the veterinary hospital for lethargy, inappetence, and possible lameness for 5 days.
The dog lives in a rural environment and is exposed to cattle and horses. It has no notable previous medical history and is not on a heartworm-, flea-, or tick-control program. The dog is fed a generic dog food purchased from a local feed store. It enjoys frequent swims in a nearby river.
Related Article: Top 5 Global Vector-Borne Diseases
A stiff gait is noted as the dog is led into the examination room. The dog is depressed and lethargic; a temperature of 104º F, dehydration, peripheral lymphadenopathy, and a slightly swollen right carpal joint are noted on physical examination. The initial diagnostic database includes hematology, synovial fluid aspirated from the right carpal joint, and lymph node tissue aspirated from an enlarged prescapular lymph node.
Diagnosis: Ehrlichiosis
Ehrlichiosis is a common tick-borne disease in dogs and cats. The Ehrlichia species that naturally infects cats has yet to be determined. In dogs, three classes of ehrlichiosis exist based on whether the infected cells are mononuclear, granulocytic, or thrombocytic. Dogs, coyotes, foxes, and jackals are considered reservoir hosts. Tick-borne vectors include Rhipicephalus sanguineus, Amblyomma americanum, Otobius megnini, and Ixodes species.
Clinical signs vary and include depression, lethargy, anorexia, mild weight loss, fever, splenomegaly, lymphadenopathy, petechiae, epistaxis, anterior uveitis, meningitis, and polyarthritis. Clinical signs can also be determined by the classification of infected cells: Hematologic abnormalities include nonregenerative anemia, thrombocytopenia, leukopenia, or pancytopenia with monocytic forms; mild thrombocytopenia/anemia with granulocytic forms; and thrombocytopenia with thrombocytic forms. Polyclonal gammopathies are common; monoclonal gammopathies have been reported.
Diagnosis is based on cytologic and/or serologic evaluation; immunoblotting and polymerase chain reaction methods are typically reserved for research and species identification. Positive results of the indirect fluorescent antibody test and enzyme-linked immunosorbent assay are the initial screening tests of choice. These tests detect serum antibodies and serum antibodies/antigens, respectively. Positive titers are not a definitive diagnosis of infection but do provide evidence if clinical signs are suggestive. Dogs in enzootic areas often have positive titers that are indicative of previous exposure with no clinical disease. Finding morulae is diagnostic. Morulae are more often observed in the subacute and acute phases of the disease and may not be detected in chronic infections. Morulae are present in low numbers in the peripheral blood cells, and a buffy coat smear is a simple, cost-effective procedure to facilitate finding them. Depending on the species of Ehrlichia, morulae can be observed in neutrophils, monocytes, lymphocytes, eosinophils, or platelets.
Related Article: Practical Guide to Tick-Borne Disease
Ask Yourself. . .
What can be noted from the hemogram?
What are the diagnostic findings on the blood smear (Figure 1)?
What is the predominate cell type observed in the cytologic evaluation of the lymph nodes (Figure 2)?
What findings are noted in the cytologic evaluation of the synovial fluid smear (Figure 3)? What are two diagnostic differentials?
What are the recommended treatment and management?
Did you answer. . .
Mild normocytic, normochromic anemia and mild thrombocytopenia.
A pale-blue, round 2.5- to 4µ diameter inclusion is present in the cytoplasm of a neutrophil (Figure 1). It is termed a morula and is morphologically indicative of Ehrlichia ewingii or equi and consistent with a diagnosis of granulocytic ehrlichiosis. The color and texture differentiate it from nuclear protein. The inclusion can sometimes appear eosinophilic.

See Figure 2. The small, mature lymphocyte (black arrow) is the predominate cell type. Higher-than-normal numbers of medium-to-large lymphocytes (gray arrowhead) and plasma cells (black arrowhead) are also noted. The cytologic findings define benign lymphoid hyperplasia (reactive lymph node). Small clumps of erythrocytes that stain greenish-gray are located to the far left and in the lower right-hand corner (gray arrow). The erythrocytes are slightly larger than the small lymphocyte and provide a perspective of size (i.e., they serve as "a micrometer"). Free nuclear protein (irregular, violet-colored structure) from ruptured cells is located at the top and to the far left.* See Figure 3. The neutrophil (arrows) is the predominate cell type in the synovial fluid. Bacterial infection of the joint and immune-mediated disease are the two most common causes of neutrophilic inflammation. No bacteria are detected after searching with the 100× (oil)-objective; it is prudent to submit a specimen for culture if sample size is sufficient. A serum tick titer panel is also beneficial. Considering the peripheral blood findings, neutrophilic inflammation is most consistent with a septic polyarthritis. In this case, it is a component of multisystemic disease associated with rickettsial infection. Normal synovial fluid contains only a small number of mononuclear cells; therefore, a cell count adds no value in defining a classification in this case. The granular, violet-colored material (circles) surrounding the cells is precipitated hyaluronic acid. Addition of acetic acid to synovial fluid precipitates hyaluronic acid and is referred to as the mucin clot test.
Ehrlichiosis is treated with doxycycline. Serologic titers typically do not become negative until 6 to 9 months after treatment and therefore are not helpful in determining resolution of disease. Clinical and hematologic improvement are indicative of successful treatment. The importance of tick control must be discussed with the owners.